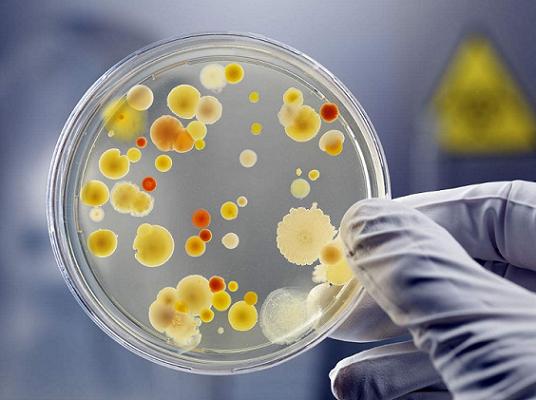
初中生物病毒和细菌的区别,生物学中细菌与病毒的区别

出品:科普中国
制作:刘馨远
监制:中国科学院计算机网络信息中心
在刚听说新型冠状病毒引起的肺炎疫情的时候,就有朋友问我,这病要怎么治疗?是不是要用很多抗生素?
实际上,治疗病毒引起的肺炎并不需要抗生素,因为抗生素是针对细菌感染的药物,对病毒感染无效。
其实,虽然都是可能让人体生病的病原体,细菌和病毒,无论是从它们自身来说,还是从致病原理、治疗方式来说,都大不相同。
虽然都很小,但细菌往往比病毒大得多
病毒和细菌是我们经常会听到的词语,但它们的差异可不少。
首先,它们的大小有差别。
细菌个体往往比较大,通过普通的光学显微镜,我们就可以轻松的观察到它们。而与之相比,病毒则会显得"娇小"一些,我们需要借助放大倍数超过万倍的电子显微镜才能揭开它的面纱。

左侧为普通光学显微镜,右侧为电子显微镜(图片来源:Veer图库)
其次,它们的细胞结构也有很大区别。细菌是由单细胞或多细胞组成的简单生物,并拥有细胞壁,而病毒并不存在这种细胞结构。

典型的细菌结构(图片来源:人教版初中生物教材)

△病毒结构比较简单,主要是蛋白质外壳包裹着遗传物质。上图为病毒的两种典型结构:左侧病毒没有包膜,右侧有包膜(图片来源见水印)
再其次,细菌可分为自养菌和异养菌,自养菌可以独立生存,广泛分布于土壤和水中,而病毒只能依靠其它生物的活细胞才能生存。
不过,细菌中的异养菌包括腐生菌和寄生菌,腐生菌指从已死的动植物或其他有机物中吸取养料,以维持自身正常生活的细菌;而寄生细菌就和病毒有相似之处了,寄生细菌寄生于生物体内,由生物提供营养和场所,如伤寒杆菌、痢疾杆菌等,但细菌大部分不会像病毒那样进入细胞,仅寄生于细胞外。
需要关注的还有它们代谢方式的不同,细菌有很多不同的代谢方式,而病毒并没有自己的代谢系统,它们只能选择通过寄生的方式依赖宿主的代谢系统来进行代谢。
细菌进入人体的"手段"比病毒丰富得多
众所周知,人类生活在各种微生物的包围之中,肉眼所及的一切范围都可能是各种病毒与细菌的聚集地,我们长期存在于这样的环境中,患病几率却没有因此而大大增加,皆因每个人都拥有各自的保护卫士——免疫系统。

图片来源:Veer图库
皮肤和黏膜是人体的第一道免疫防线,如果人体无皮肤损伤以及未被蚊虫等叮咬,病毒就无法通过皮肤进入体内,此时狡猾的病毒就只能通过呼吸道、眼睛等处于暴露状态下的黏膜进入人体。

新型冠状病毒(图片来源于搜狗百科)
因此面对此次通过呼吸道感染的新型冠状病毒,聪明的你就会知道,科学佩戴口罩可以大概率阻止病毒接触到呼吸道,从而保护我们免受病毒感染。
但对于细菌来说,虽然皮肤也是防止它进入人体的第一道屏障,但还存在不少特殊情况。

引起霍乱的霍乱弧菌就可以通过污染水源进入人体(图片来源:互动百科)
有些细菌,比如布鲁氏菌,能够打破"皮肤"这道屏障感染人体,最终可能会导致流产以及不孕不育等严重后果;而有一些致病菌,比如结核杆菌,会附着在空气中的尘埃上,伴随着我们每时每刻的呼吸从而顺利的进入我们的呼吸道;还有些细菌会选择通过消化道进入人体,比如,当我们的水源被污染后,细菌就会在水中生长,在我们饮用了这些污染的水源后,细菌就会随之进入人体。
真是太狡猾了!
病毒进入人体后,要想达到感染人体的这一可怕目的还需要进入细胞。
一般来说,病毒常见的进入细胞的方式有以下几种:注射式侵入,多见于噬菌体的侵入;细胞内吞,常见于动物病毒的入侵;膜融合,多为有包膜病毒的入侵方式。新型冠状病毒的入侵方法为细胞内吞,新型冠状病毒进入人体后,最外层的刺突蛋白能够与人的呼吸道上皮细胞表面的特异性受体结合,最终通过细胞的胞吞作用进入细胞。
此刻,你可能想问,那细菌如何进入细胞?其实大多数的细菌是生活在细胞外的,它们并不能侵染进入宿主细胞。
而当病毒进入细胞后,会开启"工作模式"。病毒会利用细胞内的能量与物质,复制、生产更多的病毒,最终通过细胞内的高尔基体分泌至细胞外,完成制造新的子代病毒的"使命"。
而相较来说,细菌的繁殖就较为自主、简单。
△培养细菌,提供营养成分即可,上图中就是一个长满细菌的培养皿。但是要想培养病毒,必须接种在活的细胞上(图片来源:http://www.bio-review.com/)
细菌一般通过二分裂的方式进行无性繁殖,个别细菌有其他的繁殖方式。
细菌分裂时,也需要进行遗传物质的复制,但如果是自养细菌的话,不需要像病毒那样借助外界力量,且在分离成两个子细胞时,不会像动植物细胞一样产生成膜体,而是细胞中部的细胞膜和细胞壁由外向内陷入,成为两个细胞。
道不同不相为谋 病毒与细菌感染人的方式并不相同
病毒之所以能让人生病,和人体自身的免疫系统有很大的关系。
当病毒入侵人体后,人体自身的免疫系统会做出应答,在消灭病毒的同时,会产生一系列的炎症反应。如果炎症反应过强,就会导致人体自身的部分细胞受损,从而释放出大量细胞内容物,机体内过多的内容物会引起免疫系统进一步工作,这种正反馈现象最终会导致人体崩溃,严重时甚至会引起死亡。
以新型冠状病毒所引发的肺炎为例,正是因为这种强烈的免疫应答发生于人体的肺部,大量免疫细胞涌入肺部参与免疫反应,才引起一系列的炎症反应、血管通透性增加,导致人体出现发热、干咳、乏力等症状,产生急速呼吸窘迫综合征、凝血功能障碍等疾病,最终导致肺功能衰竭,为我们的健康带来极大威胁。

(图片来源:Veer图库)
但是,只有一部分病毒能感染人。病毒具有自己特定的宿主,如*草烟**花叶病毒和噬菌体等,这些病毒都对人体没有特定的致病性,因此可与人和平相处。
相比于可怕的新型冠状病毒,细菌就会显得稍微可爱一些,因为绝大多数的细菌都对人和动植物无害,甚至有益,只有极少数我们称之为病原菌的细菌会对人体造成伤害,而这种病原菌致病性的强弱主要取决于两个因素-侵袭力和毒素。
侵袭力是指病原菌突破机体的防卫屏障,侵入宿主活组织并在其中生长繁殖和向四周扩散的能力,而毒素则是某些病原微生物产生的强有力的特殊毒性物质,它们可以大大增强病原菌的毒害作用。
细菌毒素可以按其来源、性质和作用的不同分为外毒素和内毒素,外毒素对组织细胞有选择性毒害效应,不引起发热,但会抑制蛋白质合成,有细胞毒性、神经毒性、紊乱水盐代谢,毒性强,微量就可以使实验动物致死;而内毒素相对毒性较弱,会引发发热、弥漫性血管内凝血、粒细胞减少血症等。
那些让我们闻之色变的致病菌之所以能引起极其严重的后果,就是因为它们有着强大的侵袭力并能在生长过程中以及死亡破裂后产生毒性极强的毒素。
病毒和细菌的区别如此之大,那么病毒感染和细菌感染有什么区别呢?
尽管病毒感染和细菌感染都有可能引发发烧、咳嗽等症状,但是细菌感染脓性分泌物会较为常见,如脓鼻涕、脓痰等,但病毒感染少有脓性分泌物。其次,细菌感染使用抗生素后,症状会明显改善,但对于病毒感染,抗生素却收效甚微,通常我们需要借助化验指标来判断到底是何种感染。
鉴于病毒感染和细菌感染的区别,我们的治疗也需要采取不同的方案,做到对症下药。病毒感染需根据病毒感染的部位不同,使用不同的抗病毒药物,同时也要注意激发、提高自身免疫力;而对于细菌感染,多选用抗生素治疗,对于不同的细菌,选用不同的抗生素。
作为病原体,病毒与细菌还是有相同之处的
作为病原体,病毒和细菌的传播方式基本相同,在人与人之间的常见传播途径有水平传播和垂直传播两种。
水平传播指病毒和细菌在人群中不同个体间的传播,主要为呼吸道或消化道传播、直接接触和性接触传播、虫媒传播和经输血注射传播等;垂直传播是指通过胎盘或产道,直接由亲代传播给子代的方式。新型冠状病毒主要通过飞沫传播和接触传播,通俗来说就是病毒感染者在打喷嚏,咳嗽,说话过程中喷出的飞沫以及呼出的气体中都带有病毒,其他人员近距离和病毒感染者接触就很有可能也被感染;还需要注意的是在密闭不通风的情况下,带有病毒的飞沫会沾染在物体表面,我们的手如果在接触这些被污染的地方而没有及时清洗消毒,此时再用手去触碰口腔、鼻腔、眼睛等黏膜,也会导致感染。

勤洗手非常重要(图片来源:Veer图库)
写到这儿,相信大家应该已经明白,为什么新冠病毒引发的肺炎不能用抗生素治疗了。如果出现了疑似症状,或者已经确诊,一定要遵从医嘱,进行治疗;如果目前并未出现任何症状,大家还是要继续加强防护,减少外出。让我们共同期待疫情的结束!

文章仅代表作者观点,不代表中国科普博览立场